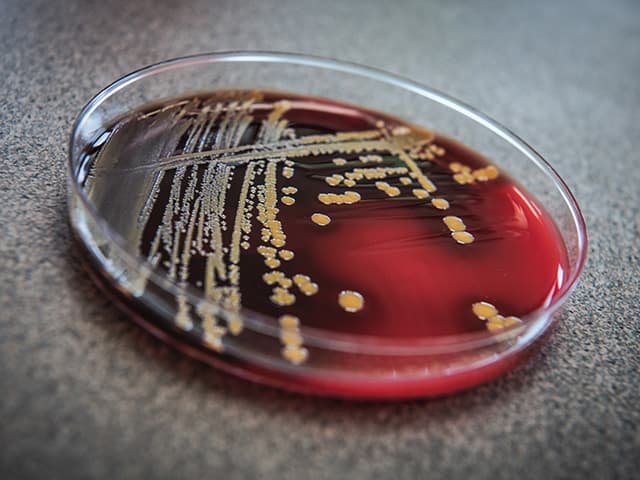
Residual Bactericidal Efficacy Testing

Antimicrobial Testing Services
Navigate complex regulatory requirements and accelerate your antimicrobial product's path to market with Element's comprehensive antimicrobial testing services. Our GLP-compliant laboratories provide the antimicrobial efficacy data you need for EPA, FDA, Health Canada, and TGA submissions, helping you demonstrate product effectiveness against emerging pathogens while meeting all regulatory standards.
Why Element are global leaders in Antimicrobial testing services
The antimicrobial sector has seen significant transformation, particularly following global health crises that have heightened awareness of infection control. The critical need to address emerging pathogens quickly has become a driving force in the sector. Element has positioned itself at the forefront of this response, helping clients combat public health threats through its specialized testing infrastructure.
With one of the few GLP-compliant Biosafety Level 3 labs in the US, Element offers capabilities that few competitors can match, particularly for high-risk pathogen testing. This strategic advantage has allowed the company to support thousands of successful product registrations with authorities including the US EPA, FDA, Health Canada, Australian TGA, and European agencies.
Element's comprehensive approach - combining microbiology, virology, and analytical chemistry - addresses the industry's growing need for streamlined, efficient testing solutions as manufacturers face increasing pressure to demonstrate both efficacy and safety while navigating complex regulatory landscapes. We eliminate the complexity of working with multiple vendors, saving you time, reducing coordination headaches, and ensuring consistency throughout your submission process.
Services we offer to the Antimicrobial Sector include:
Microbiology Testing
- Bacterial efficacy testing against 300+ organisms
- Fungal and yeasticidal efficacy testing
- Antibiotic-resistant strain testing
- GLP and non-GLP testing options
- Custom protocol development
Virology Testing
- Virucidal efficacy testing in BSL-2 and BSL-3 labs
- Testing against emerging viral pathogens (SARS-CoV-2, Mpox)
- Testing to support global regulatory submissions
- Specialized virus testing methods (suspension, carrier-based)
- Standard test methods including ASTM E1053, EN14476, and ASTM E1052 for various formulation types
Analytical Chemistry Services
- Product chemistry testing to EPA Series 830 requirements
- Stability and characterization testing
- Product-specific impurity testing
- Physical chemistry analysis
- Storage stability testing
Specialized Efficacy Testing
- Clostridium difficile (C. diff) spore testing
- Candida auris (C. auris) fungal testing
- Healthcare environment disinfection testing
- Biological aerosol and air quality claims testing
- Residual self-sanitizing activity testing
- Laundry disinfectant and sanitizer testing
- Effectiveness of Antimicrobial Preservatives testing
- Antibacterial Efficacy Testing for Soiled Dishes
- Zone of Inhibition Assay
- Cosmetic and Barrier Testing
- Wound Dressing Testing with custom protocols
- Disinfection Qualification Testing for Pharmaceutical Industry using cGMP methods
Regulatory Support Services
- Testing to support EPA, FDA, Health Canada, TGA submissions
- Development of custom protocols for unique products
- GLP-compliant testing for regulatory submissions
- Testing to satisfy specific label claims requirements
Services

Antimicrobial Microbiology Testing Services
Element's knowledgeable microbiologists can test to multiple established methods, as well as developing custom protocols.

Microbiology EN Testing services
Ensure compliance with ECHA regulations for biocidal products with Element's comprehensive microbiology EN suspension and hard surface-based testing.

Analytical Testing Services
Element provides accredited analytical testing services, supporting life sciences with regulatory compliance, tailored methodologies, and expert consultancy to streamline product development and mitigate risks.

Virology Testing
Element delivers GLP-compliant virology testing for antimicrobial products, helping companies meet global regulations, validate claims, and accelerate time to market with expert-led, reliable data.

Disinfectant Efficacy Testing Services
Element is the trusted antimicrobial laboratory partner to leading developers, manufacturers and marketers of disinfectants and sanitizers.

Microbiology Testing of Treated Articles
Element provides expert antimicrobial-treated article testing to a variety of microbiology methods, including ASTEM E2149 and ASTM E2180, AATCC 100, JIS Z2801/ISO 22196, and more.

Biological Aerosol & Public Health Air Quality Claims Testing
Element's indoor air quality testing facility is one of the first and largest of its kind in the world. Partner with us for large-scale indoor air treatment testing to meet consumer and industry demand for air treatments.

Sanitizer Microbiology Testing
Element's sanitizer microbiology testing delivers antimicrobial efficacy data for food and non-food contact products using standardized AOAC and ASTM methods, helping clients meet EPA registration requirements and overcome regulatory challenges.
Residual Bactericidal Efficacy Testing
Element's residual bactericidal efficacy testing service generates EPA-compliant data for antimicrobial products, addressing regulatory challenges and supporting product registration. Our expert testing protocols validate sustained disinfection performance on high-contact surfaces.
Your Challenges, Our Solutions
Complex regulatory navigation
Accelerating market entry
Emerging pathogen efficacy
Standards we test to and the products we test
- US EPA 810
- ECHA - BPR guidance
- Australia TGA
- Health Canada
- EPA MLB SOP MB-28
- EPA MLB SOP MB-31
- EPA MLB SOP MB-35-00
- EPA MLB SOP MB-37-00
- ASTM E1053
- EN14476
- ASTM E1052
- ASTM E2274 and E2406
- AOAC Method 955.17
- ASTM E2315
- ASTM E2149
- AOAC Method 965.13
- AATCC 100
- USP <1072> for disinfectant qualification methods
Antimicrobial Products
- Liquid disinfectants
- Pre-saturated towelettes
- Treated surface materials
- Antimicrobial pesticide devices
- Aerosol disinfectants
- Fogging devices
- Laundry disinfectants and sanitizers
- Treated articles
- Preservative systems
- Cosmetic antimicrobials
- Wound dressings
- Barrier materials
- Swimming pool disinfectants
- Textile antimicrobial finishes
Pathogens Tested
- Extensive bacterial library (300+ organisms)
- Viral pathogens including SARS-CoV-2 and Mpox
- Fungal organisms including Aspergillus, Candida, Penicillium, and others
- Antibiotic-resistant strains including MRSA, VRE, MDR, and carbapenem-resistant organisms
- Clostridium difficile (C. diff)
- Candida auris (C. auris)
- Emerging pathogens
Differentiate your products with claims supported by our comprehensive organism libraries. With hundreds of bacterial and fungal organisms, antibiotic-resistant strains, and viruses at our disposal, you can substantiate specific claims that set your products apart in the marketplace. Our microbiologists continuously monitor for emerging pathogens, ensuring your testing stays relevant to current public health concerns.
Why Choose Element

Industry-leading experience
Comprehensive testing capabilities
One-stop testing solution
Client-centered approach
30+years
1000s of successful product registrations
300+ pathogen testing library


